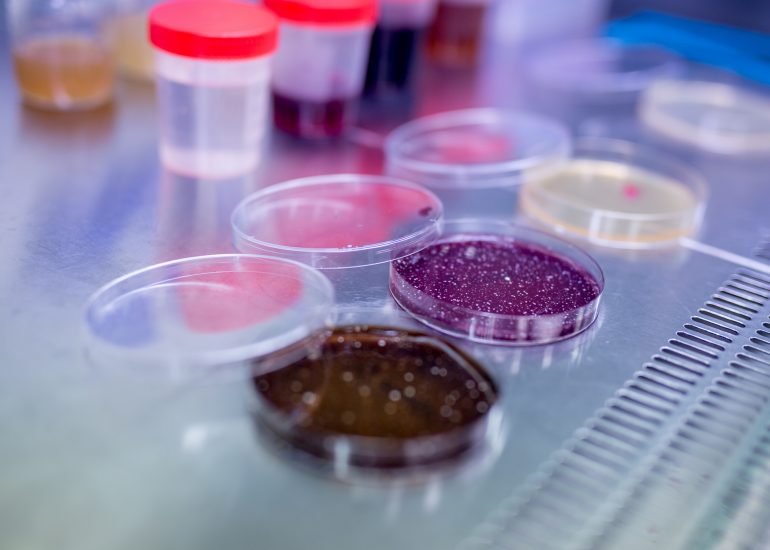

Creemos que las empresas también tienen alma
Fotografiamos el espíritu de tu empresa
Más allá del reportaje empresarial
Las empresas tienen alma y su propia filosofía. Es lo que fotografiamos.
Creemos que un reportaje fotográfico de una empresa debe reflejar su actividad y procesos. Pero también su alma, la filosofía que impulsa todos los días a abrir la puerta. El espíritu del equipo.